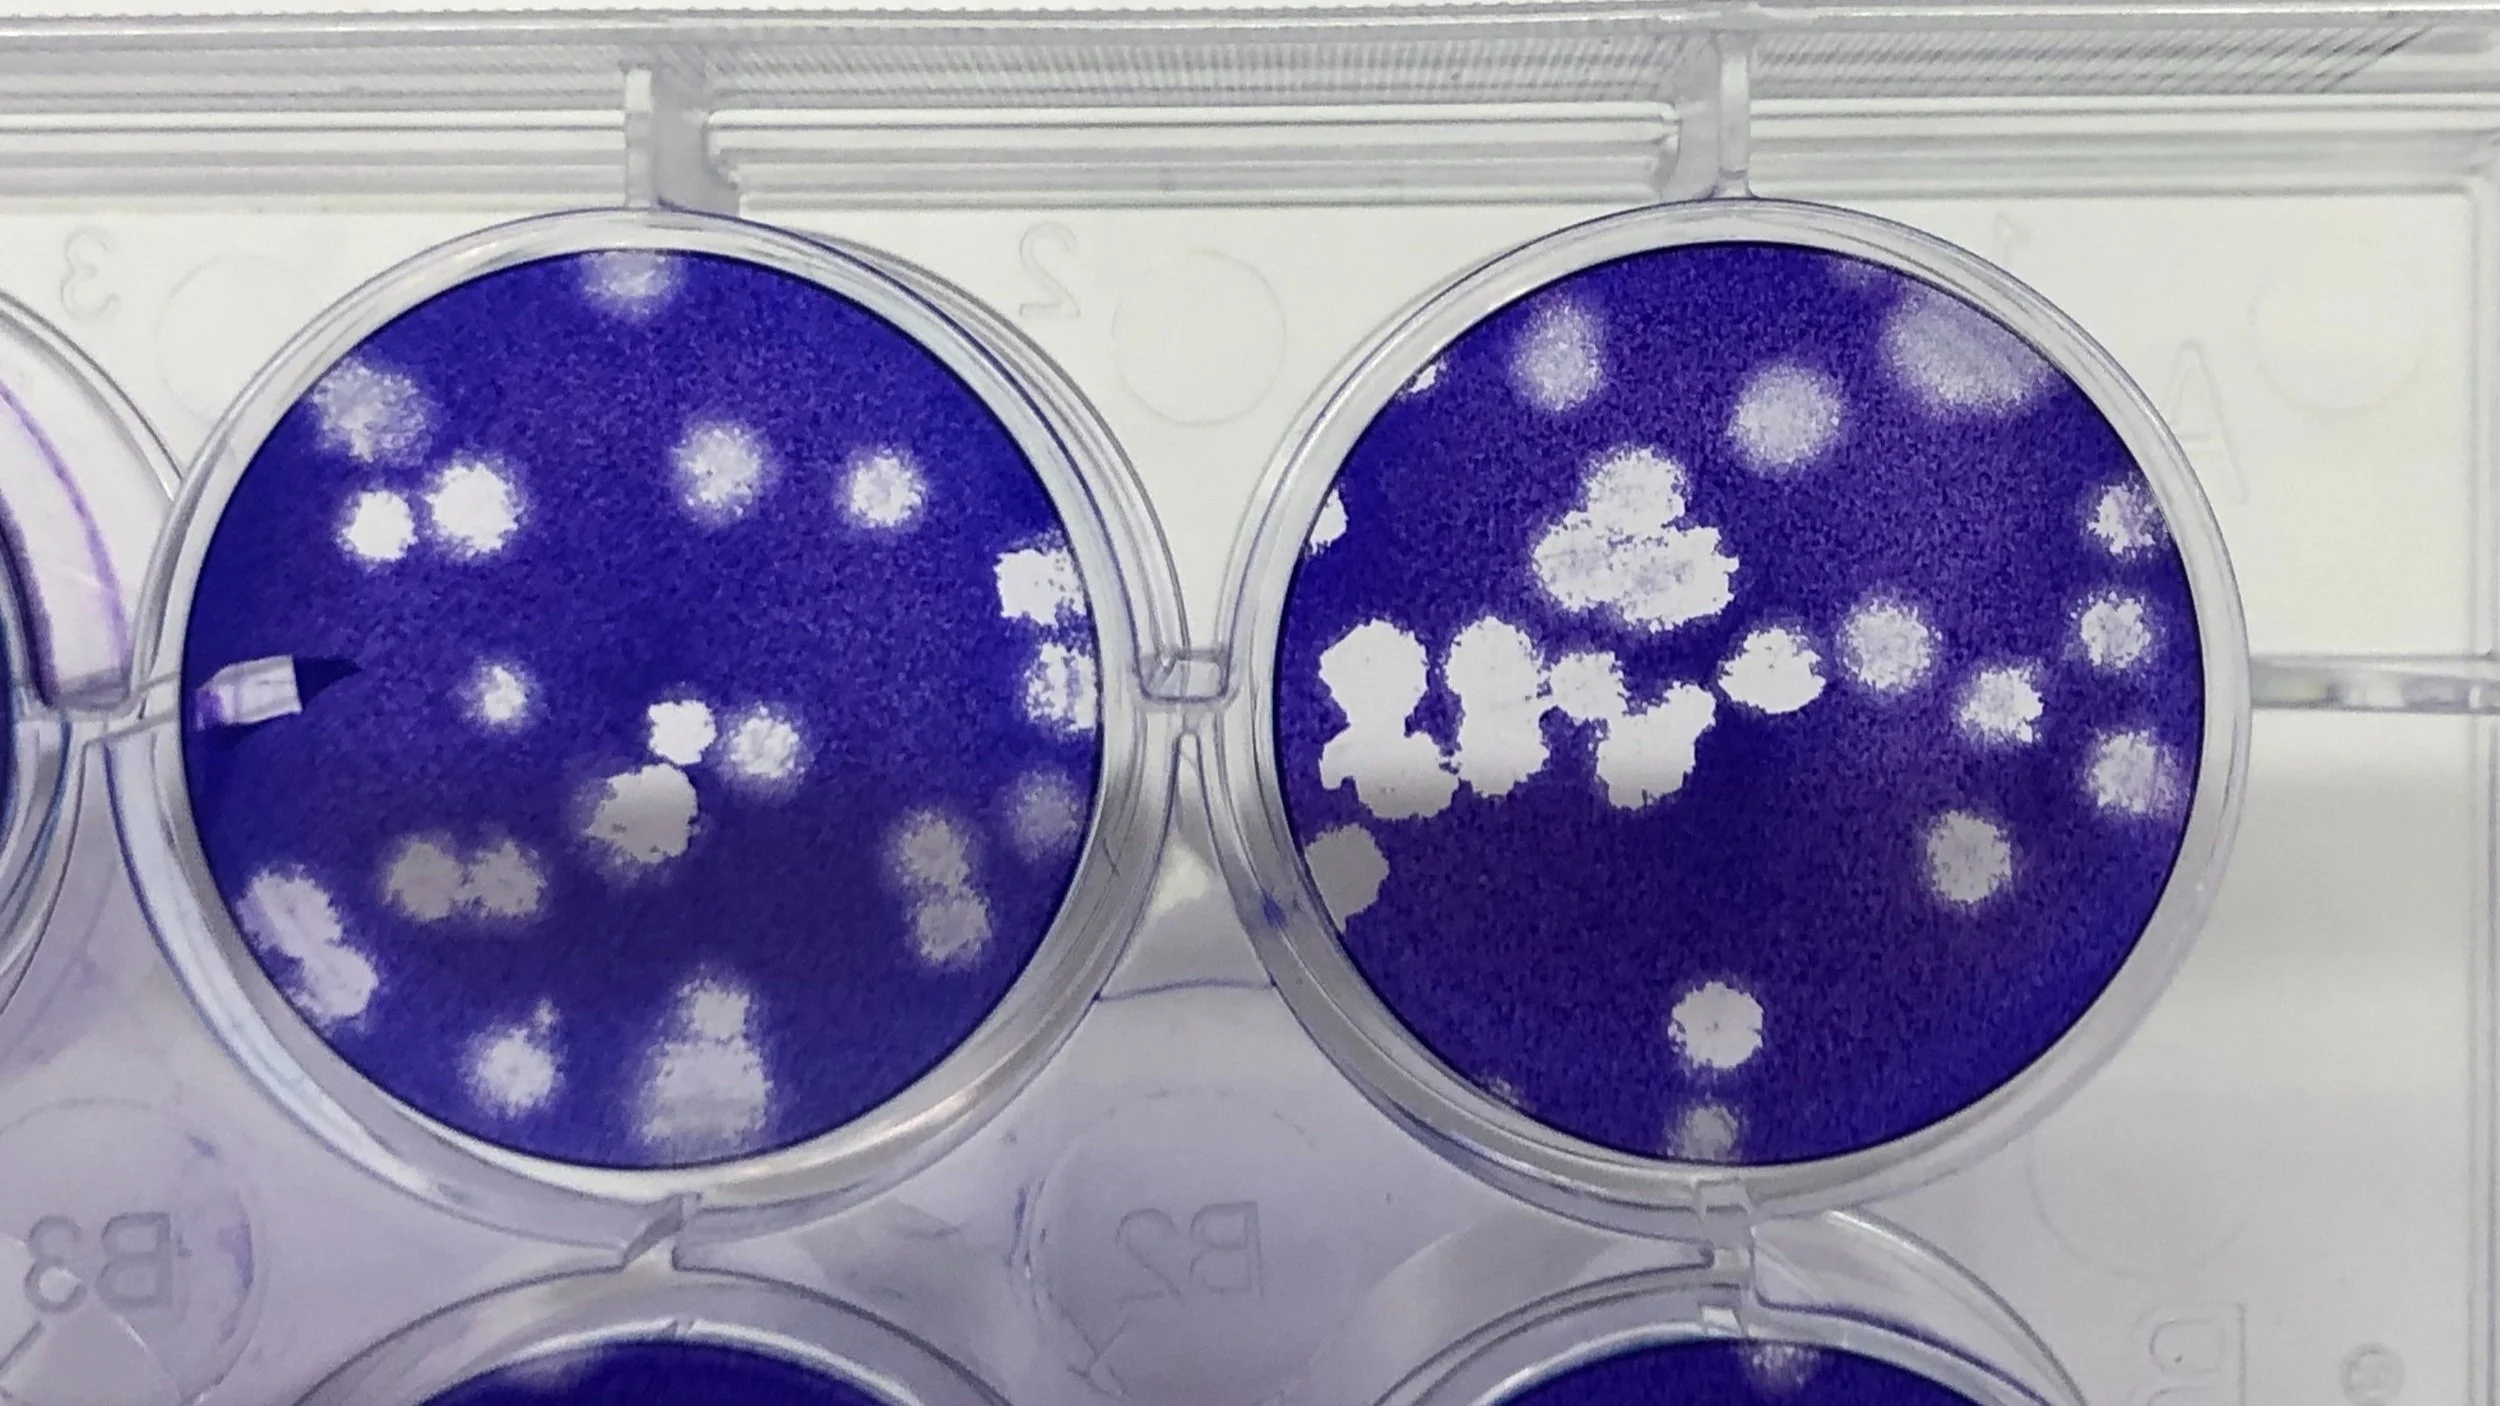

Student Alumni
Kaleigh Connors, PhD - January 2025. Thesis: “Rift Valley Fever Virus Infection in Neurons” Defense 1/6/2025. Current: medical writer.
Maris Pedlow, MS - April 2025. Thesis: Neurotropism of Oropouche virus and the efficacy of a pan-bunyaviral endonuclease inhibitor. Defense 4/11/2025. Current: EH&S Biosafety.
Kaleigh Connors, PhD – April 2025. Thesis: “Rift Valley fever virus infection of neurons” Defense 1/6/2025. Current: post-doctoral asscociate, Hartman Lab.
Zachary Frey, BS (Neuroscience Major) - April 2023. Senior Thesis title: “Characterizing Jamestown Canyon virus infection of primary rat neurons and dependence on Lrp1.” Current: PhD student, UNC.
Bayley Fields, MPH - April 2023. Essay title: “Genetic Polymorphisms in LRP1, a newly identified receptor for emerging Bunyaviruses.” Current: Epidemiologist
Madeline Schwarz, PhD - April 2023. Thesis: “Lrp1 is an essential host factor for Rift Valley fever virus and other bunyaviruses.” Defense: 3/6/23. Current: Scientist at Abound Bio.
Zachary Koenig - MS degree awarded April 2020. Thesis: “Type III Interferon Control of Rift Valley Fever Virus Infection at Epithelial Cell Barriers.” Earned his PhD student at University of Cincinnati (defense Sept 2025).
Devin Boyles - MS degree awarded December 2019. Thesis: “Determining the cellular targets and resulting pathology of Rift Valley Fever virus infection of the rat CNS and reproductive system using microscopy.” Current: MRI Global.
Tiffany Thompson - MPH degree awarded June 2017. Essay: "A Literature Review of the Histology of Rift Valley Fever Virus Neurological Disease Comparing Rodent and NHP Models to Human Disease."
Joseph Albe - MPH degree awarded April 2017. Thesis: "Viral encephalitis: phenotyping leukocyte infiltration into the central nervous system as a result of Rift Valley fever virus infection." PhD student at the University of Washington (defended October 2025). Current: Washington Research Foundation, Seattle: https://www.wrfseattle.org/about-us/our-team/
Noah Salama - MS degree awarded April 2017. Thesis: "Analysis of peripheral immune responses for the development of an encephalitis non-human primate animal model for new world alphaviruses." Current: MD/PhD student at University of Rochester.
Aaron Walters - MS degree awarded December 2016. Thesis: "The effect of infection route on disease outcome in rats infected with Rift Valley fever virus." Current: US Well Services in Bryan, TX.
Michael Kujawa - MS degree awarded April 2016. Thesis: "Understanding the neuropathogenesis of Rift Valley Fever using in vitro and in vivo models." Current: IBC Coordinator and Biosafety Specialist, Biorisk Management Branch, Occupational Health and Safety, National Institutes of Health, Bethesda, MD.
Jonathan Berback - MPH-PEL degree awarded December 2015. Thesis: "Antiviral activity of primary human trophoblast conditioned media against Rift Valley Fever virus." Current: Infection Preventionist, Lehigh Valley Health Network
David Jung - MPH-PEL degree awarded December 2015. Thesis: "Efficacy and Cytotoxicity of Novel Antiviral Compounds Against Rift Valley Fever Virus." Current: Biosurveillance Specialist, Noblis
Amy L. Caroline - MS degree awarded April 2013. Thesis: "Characterization of the humoral immune response in rats and non-human primates exposed to aerosolized virulent Rift Valley Fever virus."
Staff Alumni
Zach Frey (Research Technician)
Ryan Hoehl (Research Technician)
Matt Demers (Research Technician/Lab Manager)
Joseph Albe (Research Technician)
Devin Boyles (Research Technician)
Jeneveve Lundy (Veterinary Technician)
Michael Kujawa (Research Technician)
Jen Symmonds (Veterinary technician)
Aaron Walters, MS (Research Technician)
Tiffany Thompson, MPH (Research Technician)
Amy L. Caroline (Research Technician)
Jacquelyn M. Bales (Research Technician)
Diana Powell (Veterinary Technician)
Laura Bethel (Research Technician)